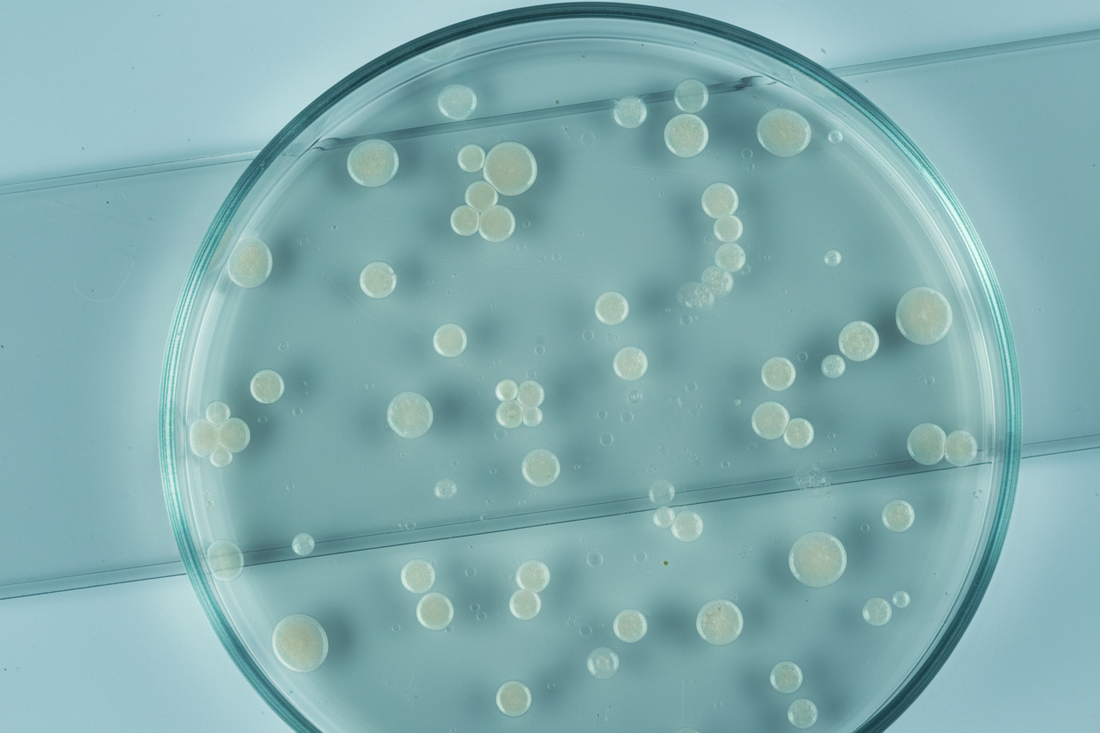
Bacteria growth on agar plate

The Ryatt Guide
It's not just your makeup brushes that need cleaning
Common makeup brush cleaning mistakes
Why cleaning your makeup brushes is non-negotiable
How to clean makeup brushes